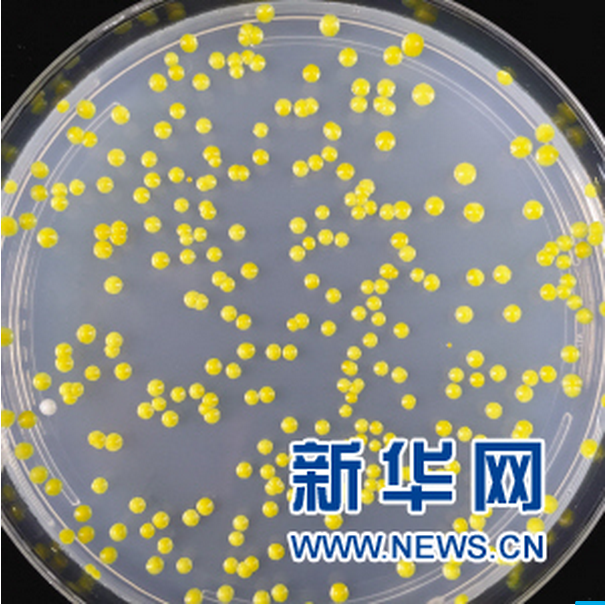

新华网天津10月27日电(张建新 赵晖)25日教育部公布文件对天津大学合成生物学前沿科学中心予以立项建设。揭秘生命起源,抢占生命再造最高峰,孕育引领新经济的颠覆性成果,天津大学合成生物学前沿科学中心作为教育部首批前沿科学中心被寄予厚望,旨在建设成为具有国际“领跑者”地位的创新中心和人才摇篮。这也是天津首个批准立项建设的前沿科学中心。

合成生物学搭建了从物质到生命的蜕变通道,该技术利用天然或人工生物学元器件对生命进行设计、改造乃至重新合成,开创了“生命再造”的新纪元。DNA存储,几公斤介质可能取代绵延数十万平方米的数据存储中心;基因线路设计,能调控免疫系统,治愈癌症;人工合成基因组,可能解决耐药性,终结超级病毒;人工牛奶、高能燃料乃至超级战警……合成生物学让未来充满无限可能。合成生物学被誉为将引起人类生活以及全球经济发生革命的颠覆性技术,对人类健康、经济与安全产生深远影响。欧美等发达国家已经将发展合成生物列入国家战略。为在关键领域占领科技制高点,教育部批复建设的首批六个前沿科学中心就包含天津大学合成生物学前沿科学中心。

天津大学在我国率先开展合成生物学研究,是我国合成生物学基础研究领域的重要创新力量,围绕合成生物学主要研究方向,形成了包括院士、长江、杰青、青千、优青等组成100余人的研究队伍,在基因组合成、基因回路理论和设计、人工生物系统设计构建等领域取得了重要突破和一批科技成果。其中,酵母基因组合成再造成果实现真核染色体合成突破,为研究染色体重排、癌症、衰老、人类染色体异常疾病等提供了新的研究思路和研究模型,使我国成为继美国之后第二个掌握真核生物基因组设计构建能力的国家。
根据规划,经过5-10年的建设,天津大学合成生物学前沿科学中心将在实现前瞻性基础研究和引领性原创成果的重大突破,在部分方向实现国际领跑;产出一批共性关键技术、前沿引领技术、颠覆性创新技术、核心关键技术,为医药健康、生物安全、生物化工、绿色能源、环境保护、现代农业等提供科技支撑;建设成为“国际开放”和“全球视野”的世界顶级研究中心;打造具备战略性、国际化、建制性的专业技术人才梯队,培养一支300人左右以年轻科学家为主的创新团队。

教育部对天津大学合成生物学前沿科学中心寄予厚望,立项建设的通知中明确了建设目标——建成具有国际“领跑者”地位的创新中心和人才摇篮。据悉,该中心将聚焦国家重大需求,聚焦世界科技发展前沿,探索人工生命体的设计构建原理,发力于重大基础理论和关键核心技术的研究,力争在“绿色生物制造”“人类健康”领域实现重点突破。该中心的技术创新目标是:突破人工基因组合成、人工细胞工厂精准构建等重大基础科学与技术难题,获得标志性成果,促进合成生物技术产业化。该中心将建设DNA生物信息与人工器件、DNA智能制造、元件模块底盘库、合成生物技术转化、生物安全中心等5个共性关键技术研发平台,主要研究方向包括合成基因组学、人工细胞设计构筑、光电驱动人工合成系统、合成生物学新理论与新技术。
根据中心建设要求,天津大学将提供充足的空间,加大人才引进力度与政策倾斜,按照教育部要求,把天津大学合成生物学前沿科学中心建设作为世界一流大学和一流学科建设的重要抓手,结合“双一流”建设规划布局,汇聚整合各类创新资源,发挥学科群优势,面向世界汇聚一流人才团队,促进学科深度交叉融合,建设体制机制改革示范区,率先实现前瞻性基础研究、引领性原创成果的重大突破,在关键领域自主创新中发挥前沿引领作用。
新华网:http://www.tj.xinhuanet.com/tt/2018-10/27/c_1123621353.htm
(编辑 焦德芳 赵宇欣)